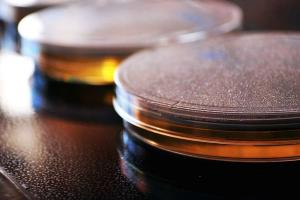

Because of You, 2.2 Million Students Are Being Formed in the Faith
Because of generous supporters like you, Catholic Online School has already delivered free, faithful Catholic education to over 2.2 million students across 193 countries. In an age of noise and algorithms, you are helping form souls with truth, prayer, Scripture, and Christ.
If everyone who reads this gave just $5 — the cost of a coffee — we could reach even more families and keep this life-changing formation free for all. Be Courageous. Be Catholic. Stand with us today.
DONATE TODAY >Bioethicist responds to Japan's approval of human-animal hybrid research
FREE Catholic Classes
The Japanese government is expected to approve funding for a research project, led by stem cell scientist Hiromitsu Nakauchi, to use stem cells to create animal embryos that contain human cells.
Highlights
Washington D.C., (CNA) - Father Tad Pacholczyk, Director of Education at the National Catholic Bioethics Center, told CNA that the research involves the implantation of human cells, typically human stem cells, into non-human animal embryos, such as embryos from pigs and sheep, for the purposes of growing human hearts, kidneys, and other organs in those animals.
"These organs would be generated for potential use in organ transplantation situations and to alleviate organ shortages...which could be a very helpful development for many people currently on the waitlist for an organ," Pacholczyk explained.
"The aim is to make one species grow an organ of the other, rather than seeking to somehow 'combine' two species into a new, third species."
That being said, however, Pacholczyk warned that if such research must be done, it should not include the creation or destruction of human embryos.
In general, he said, research destructive of human embryos is always morally unacceptable, because it involves "the purposeful destruction of younger humans to serve the interests of older and more wealthy humans."
The Pontifical Academy for Life stated its 2000 Declaration on the production and the scientific and therapeutic use of human embryonic stem cells that "on the basis of a complete biological analysis, the living human embryo is - from the moment of the union of the gametes - a human subject with a well-defined identity," and that as "a human individual it has the right to its own life; and therefore every intervention which is not in favor of the embryo is an act which violates that right."
These will not be the first experiments done involving human-animal hybrid embryos, but it is the first to receive official support from a government. The National Institutes of Health in the US has had a moratorium on funding such work since 2015, according to Nature.
Nakauchi is the director of the Center for Stem Cell Biology and Regenerative Medicine at the University of Tokyo and team leader at Stanford's Nakauchi Lab. He is still awaiting final approval from the Japanese government to begin his research.
Nakauchi told Tech Explorist that he plans to inject animal embryos, which have been engineered to lack a specific organ such as the pancreas, with human stem cells in order to see if they can grow the missing organ using those cells.
Rather than embryonic stem cells, Pacholczyk said, the researchers should consider using adult stem cells�" typically harvested from the bone marrow consenting adults�" or what are known as induced pluripotent stem cells, which are adult cells that have been genetically reprogrammed to an embryonic stem cell�"like state.
"These kinds of experiments require very careful ethical discernment, and the scientific community, with ethical input from the Church and appropriate outside regulatory control, must adhere to clear moral lines, meaning they need to agree that there are practices they will not do," Pacholczyk said.
"This kind of research has the potential to be done in an ethical way, and to produce solid scientific advances, or in various unethical ways and to result in harmful and controversial scientific practices."
Japanese scientists were previously forbidden from allowing human cells to grow within other animals past a 14-day period, but in March the government relaxed the rules on embryonic stem-cell research aimed at creating human-animal hybrids, allowing such creations to be brought to term.
Bioethicists have raised the possibility that human cells might stray beyond development of the targeted organ, travel to the developing animal's brain and potentially affect its cognition, Nature reports.
To that end, Pacholczyk said that for any chimeras - third, hybrid animals�" produced, care must be exercised to avoid the replication of major pillars of human identity in animals, such as the brain system.
In addition, chimeras which produce human sperm or human eggs should never be generated, he said, to avoid the production of the basic building blocks of human reproduction.
The Japanese scientist plans to begin with mice and rats, experimenting for two years, and said it is his hope to eventually apply for government approval to grow human-pig hybrid embryos for up to 70 days.
"Human cells generally do not grow very well in pigs or sheep, likely due [to] the evolutionary distance between us and them, so additional 'tricks' and genetic manipulations may be needed to help the human cells grow," Pacholczyk commented.
"There is also a chance of transmitting new viruses from, say, pigs into the human organs that the pigs are growing, so this will have to be carefully addressed to be sure that if such organs were ever used in transplants, humans would not become susceptible to new infections."
In the US, the NIH proposed in 2016 federal funding of projects to possibly create a human-animal hybrid, prompting serious moral and legal concerns from Catholic ethicists.
In comments submitted to NIH at the time, the National Catholic Bioethics Center stated that using human embryonic stem cells for research is wrong because "human beings at these vulnerable stages must be safeguarded, not exploited, in both clinical and research settings."
---
'Help Give every Student and Teacher FREE resources for a world-class Moral Catholic Education'
Copyright 2021 - Distributed by Catholic Online
Come Grow With Us
Sign up and walk the Catholic journey with millions around the world.
Receive inspiring emails on saints, daily readings, and free faith-building resources—no cost, ever.
Sister Sara Has One Message for Every Catholic Family This June
- 7 Morning Prayers
- Mysteries of the Rosary
- Litany of the Bl. Virgin Mary
- Popular Saints
- Popular Prayers
- Female Saints
- Saint Feast Days by Month
- Stations of the Cross
- St. Francis of Assisi
- St. Michael the Archangel
- The Apostles' Creed
- Unfailing Prayer to St. Anthony
- Pray the Rosary
![]()
Copyright 2026 Catholic Online. All materials contained on this site, whether written, audible or visual are the exclusive property of Catholic Online and are protected under U.S. and International copyright laws, © Copyright 2026 Catholic Online. Any unauthorized use, without prior written consent of Catholic Online is strictly forbidden and prohibited.
Catholic Online is a Project of Your Catholic Voice Foundation, a Not-for-Profit Corporation. Your Catholic Voice Foundation has been granted a recognition of tax exemption under Section 501(c)(3) of the Internal Revenue Code. Federal Tax Identification Number: 81-0596847. Your gift is tax-deductible as allowed by law.









